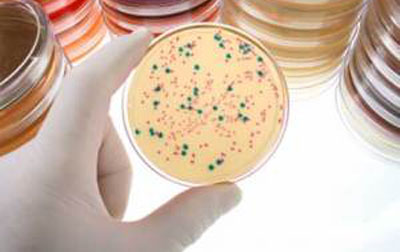

qARTA Bio Products
Products
| Real-Time Plasticware and Reagent Kits |
|---|
| Qiagen Rotor-Gene Q Compatible |
| ABI Compatible |
| qPCR |
| EvaGreen® master mixes |
| Probe master mixes |
| HRM EvaGreen® mixes |
| PCR |
| Hot taq master mixes |
| Taq Master Mixes |
| Hot taq kits |
| Standard taq kits |
| Nucleotides |
| dNTP Mixes |
| dNTP Sets |
| Individual dNTPs |
| Gene expression |
| qARTAcillin™ |
| X-Gal and IPTG Spray |
| Loading Dye Buffers |
| 6X Loading Dyes |
| DNA Colorants |
| q•Blue Colorant |

qARTA X-Gal and IPTG Spray | ||||||
| Catalog No. | Description | Volume | Size | |||
|---|---|---|---|---|---|---|
| R121 | X-Gal/IPTG Spray | 20 mL | 100 plates | |||
|
Click here for your FREE SAMPLE |
|
qARTA X-Gal and IPTG Spray lets you do Blue-White colony screening without all the hassle. You won't need to weigh X-Gal or IPTG. You won't need to measure DMSO or DMF. Recommended Usage Protocol:
For complete usage instructions download full User Protocol. |
|
||||||||
|
|